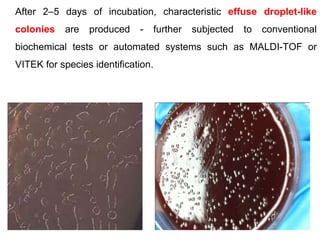
After 2–5 days of incubation, characteristic effuse droplet-like
colonies are produced - further subjected to conventional
biochemical tests or automated systems such as MALDI-TOF or
VITEK for species identification.

Campylobacter and Helicobacter are Gram-negative, microaerophilic bacteria. Campylobacter species cause diarrheal disease and are commonly found in animal intestines. C. jejuni is the most frequent cause of foodborne illness. Helicobacter pylori colonizes the stomach and is associated with peptic ulcer disease and gastric cancer through production of toxins and induction of inflammation. Diagnosis involves culture, biopsy tests detecting urease activity, and breath and stool antigen tests. Both genera are important human and animal pathogens.


![Campylobacter
• 0.2-0.5 µ thick and 0.5-5 µ long.
• Gram –ve bacilli & pleomorphic.
• Non sporing
• Motile [darting / tumbling] single polar flagella.
• Resemble vibrio but differ
– Microaerophilic
– Not fermenting sugars
– Lower G+C content of DNA.](https://image.slidesharecdn.com/campylobacterhelicobacter-230721060334-c2045785/85/Campylobacter-Helicobacter-ppt-3-320.jpg)

![Species other than jejuni
• C. coli
• Diarrhea
• C.concicus
• Gingivitis &
periodontal disease
• C.fetus (370C)
• Abortion in cattle &
sheep
• Septicemia
• C. hyointetinalis
• Diarrhea & proctitis
[homosexuals]
• C.lari
• Diarrhea
• C.sputorum
• Diarrhea &
septicemia](https://image.slidesharecdn.com/campylobacterhelicobacter-230721060334-c2045785/85/Campylobacter-Helicobacter-ppt-17-320.jpg)






















